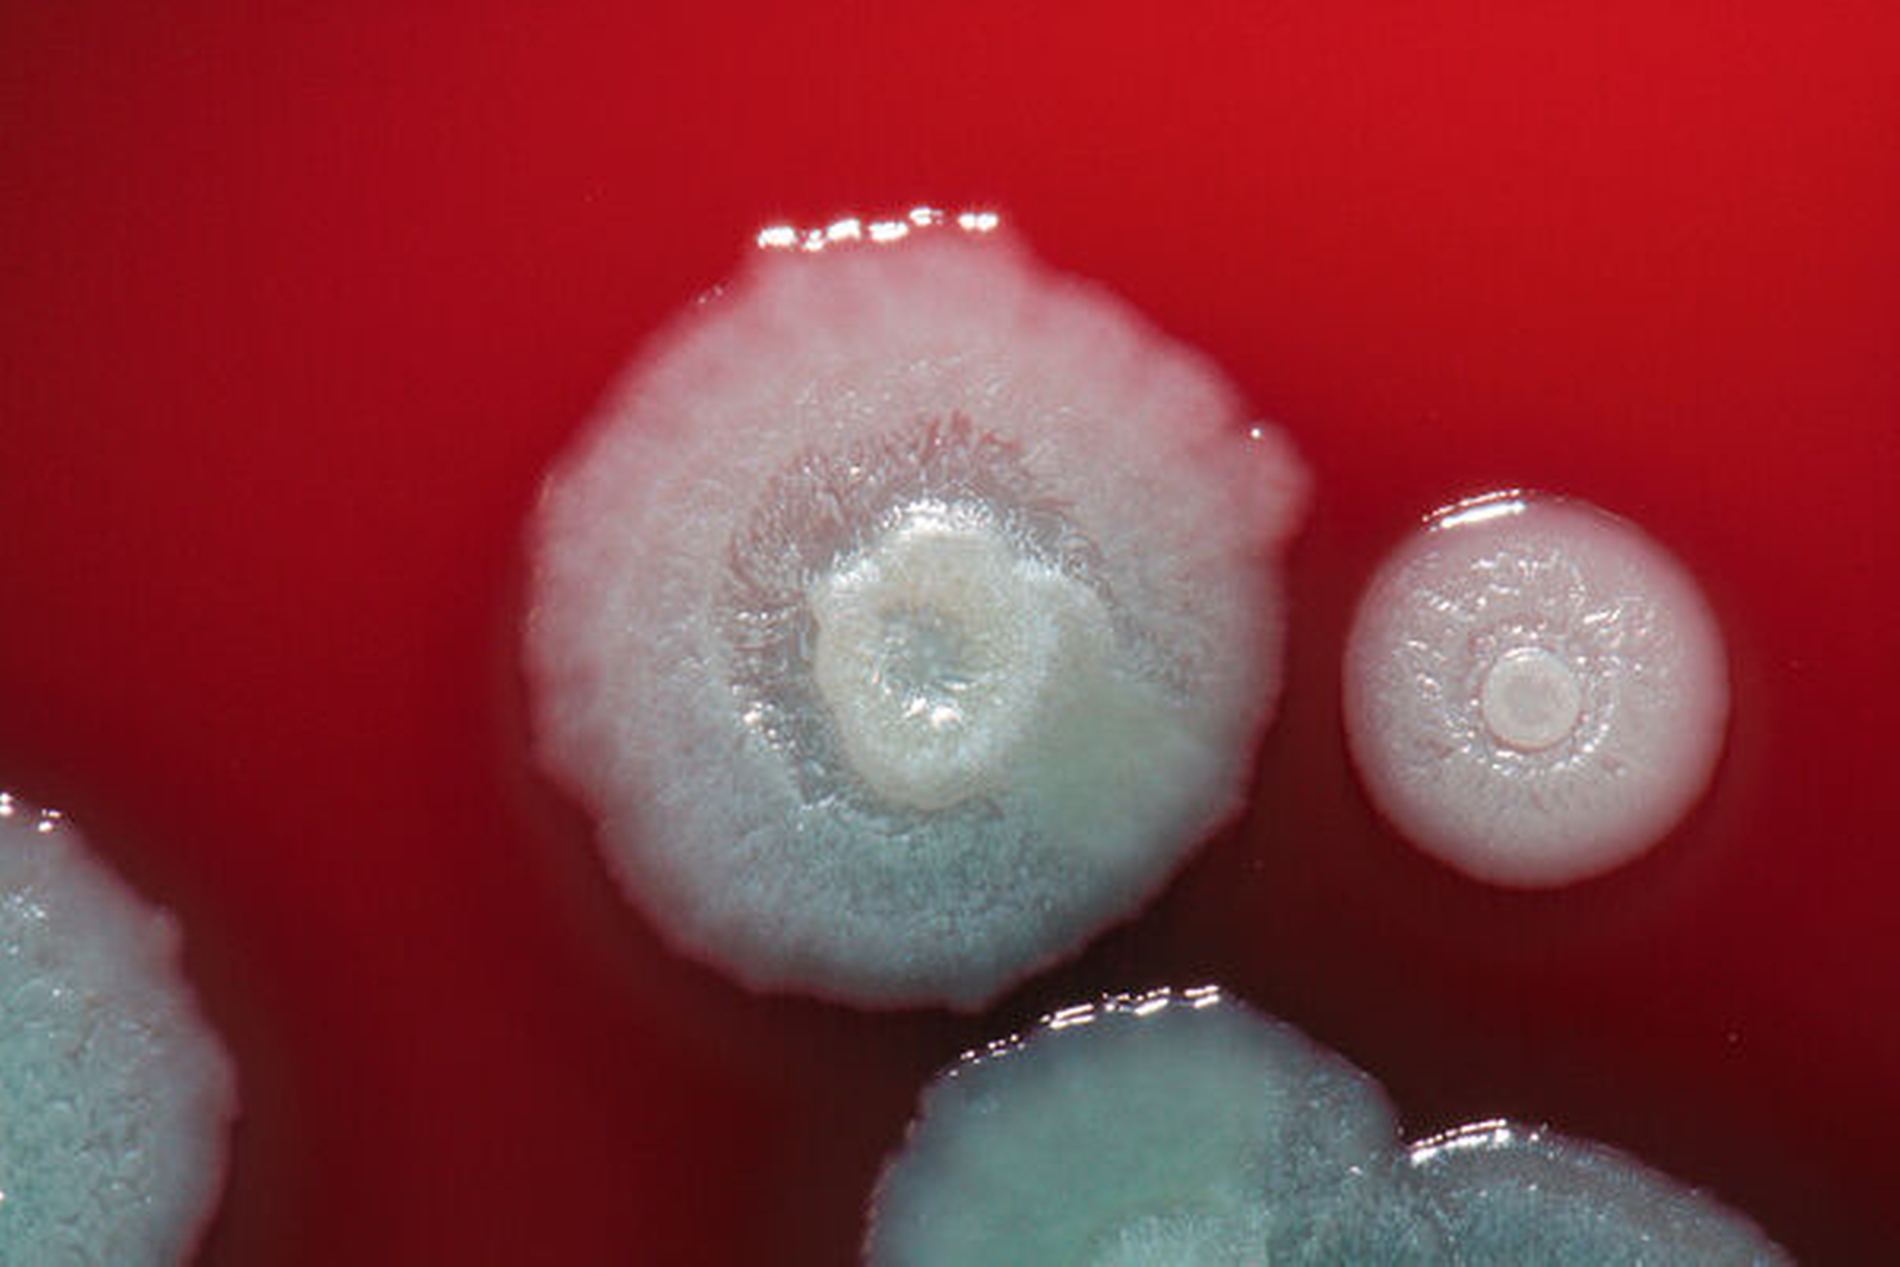

Untypische Auslöser odontogener Abszesse
Abszessgeschehen odontogener Ursache sind seit dem Beginn medizinischer Aufzeichnungen bekannt [Heim et al., 2017]. Um das Jahr 1600 wurden erstmalig systematisch die Todesursachen der Einwohner von London dokumentiert. Das Krankheitsbild rangierte hier zeitweilig auf Platz fünf. Dies zeigt, dass der Ausgang dieser Entzündungen unbehandelt lebensbedrohlich sein kann – damals wie heute.
Etwa vier Prozent aller stationär behandelten Fälle in deutschen Abteilungen für Mund-, Kiefer- und Gesichtschirurgie entsprechen odontogenen Abszessen, was diesem Krankheitskomplex eine erhebliche gesundheitsökonomische Bedeutung zukommen lässt. Beherdete Zähne sind als Fokus die häufigste Ursache von Infektionen im Kopf- und Halsbereich. Die Entitäten der polymikrobiellen Infektionen sind insuffiziente Wurzelkanalbehandlungen und infizierte Augmentationsmaterialien, Perikoronitis, dentale Traumata, verlagerte Zähne und Infektionen des Zahnhaltehalteapparats, die die Migration von Mikroorganismen in den subapikalen Bereich fördern können. In der Folge kommt es zu deutlichen Schwellungen mit Überwärmung, Druckdolenz und Schmerzen (Abbildung 2).
Die Therapie der Wahl besteht, – wie bei allen Abszessen – in der chirurgischen Eröffnung (Abbildung 3) und Drainage. Inzision und Drainage gelten hier nicht nur dem Abfluss des Pus, sondern sorgen darüber hinaus für die Penetration von Sauerstoff in die Abszesshöhle, was die anaeroben Erreger aufgrund ihrer Stoffwechseleigenschaften deutlich dezimiert (Abbildung 4).
Ob ein Patient einer stationären Behandlung zugeführt werden muss, ist von einer ganzen Reihe von Faktoren abhängig. Bei Symptomen wie Fieber, Schluckbeschwerden, Atemnot, bei klinisch bereits sichtbaren Ausbreitungstendenzen in weitere Logen oder bei Grunderkrankungen wie Diabetes mellitus wird in der Regel die stationäre Überwachung eingeleitet [Heim et al., 2020]. Unterstützende intravenöse Antibiotikatherapien werden in diesen Fällen oftmals durchgeführt, um die systemische Reaktion der Infektion einzudämmen. Zunächst werden hier kalkulierte Präparate eingesetzt, bis eine Erregerbestimmung und die Anfertigung eines Antibiogramms etwaige antibiotikaresistente Erreger identifiziert und die antimikrobielle Therapiestrategie angepasst wird.
Die prompte Durchführung der chirurgischen Therapie verhindert meist septische Verläufe und die Ausbreitung in besonders sensible Gewebe (Orbita, Mediastinum, Wirbelsäule oder Neurokranium) sowie die Verlegung der Atemwege, die zu vital bedrohlichen Komplikationen führen kann [Heim et al., 2019]. Es folgt die regelmäßige Spülung der Abszesshöhle mit desinfizierenden Lösungen (zum Beispiel Betaisadona) (Abbildung 5).
Antibiotikaresistenzen und mikrobielles Spektrum
Die bakterielle Flora odontogener Abszesse ist eine Mischflora, bestehend aus aeroben, fakultativ anaeroben und strikt anaeroben Keimen. Meist ist es nicht einfach, aus dem Erregergemisch einen bestimmten Keim zu isolieren, der als Abszessauslöser eindeutig zu identifizieren ist. Die Unterscheidung zwischen Begleitflora und Erregern lässt sich in vielen Fällen nicht eindeutig vornehmen.
Als häufige aerobe Erreger sind grampositive Kokken wie Strepto- und Staphylokokkenstämme anzutreffen. Zusätzliche Erreger wie Enterococcus faecalis, Klebsiella species, Neisseria species, Capnocytophaga gingivalis, Lactobacillus species, Actinobacillus actinomycetemcomitans und Eikenella corrodens sind ebenfalls häufig nachweisbar [Heim et al., 2020]. Die häufigsten anaeroben Keime sind Prevotella species, Peptostreptococcus und Porphyromonas species. Neben Veillonella sind weitere regelmäßige Vertreter Bacteroides und Fusobacterium species.
Die einzelnen Erreger scheinen dabei topografiespezifisch aufzutreten. Die Zahnoberfläche wird insbesondere von Aktinomyceten sowie Streptokokkus sanguinis, mitis und mutans besiedelt. Zunge und Wangenschleimhaut wird vermehrt von Streptokokkus salivarius und Veillonella kolonisiert, während die übrigen gingivalen Gewebe vor allem von Prevotella-Spezies, Porphyromonas, Fusobacterien und Spirochären besiedelt werden.
Insgesamt scheint sich bei odontogenen Infektionen das Gefährdungspotenzial zu erhöhen – sowohl im Hinblick auf den Schweregrad als auch auf höhere Resistenzzahlen gegen gängige Antibiotika und auf eine Verschiebung der Zusammensetzung der Flora. So zeigten sich in eigenen Untersuchungen bei fast jedem zweiten isolierten Streptokokkusstamm und bei beinahe jedem vierten Staphylokokkusstamm Resistenzen gegen gängige Antibiotikapräparate. Hinzu kamen Resistenzen gegen sogenannte Reserveantibiotika, die für Patienten zurückgehalten werden, bei denen die routinemäßig verwendeten Präparate aufgrund von ausgeprägten Resistenzlagen keine Wirkung mehr zeigen. Sowohl gegen Meropenem als auch gegen Teicoplanin und Vancomycin ließen sich in mehreren Fällen Bakterien mit Resistenzen aus odontogenen Abszessen isolieren [Heim et al., 2020].
Im Umkehrschluss bedeutet dies für die Behandlung von Abszessen in der Praxis, dass Resistenzen gegen beispielsweise Penicillin keine Ausnahme sind und gegebenenfalls rasch progrediente und schwere Verläufe von odontogenen Abszessen mit den bekannten Präparaten zum Teil nur schwer oder nicht in den Griff zu bekommen sind. Um so mehr ist eine suffiziente chirurgische Therapie in Fällen von Abszedierungen angezeigt. Eine Früherkennung oder klinische Differenzierung, mit welcher Art von Erreger man es zu tun hat, gibt es leider klinisch nicht. Erst der Abstrich und die Bakterienanzucht kann die Identifizierung möglich machen, dauert aber in jedem Fall mehrere Tage.
Seltene Erreger
Neben den üblichen pathogenen Mikroorganismen haben wir in einer groß angelegten Studie einige überraschende und seltene Abszess-auslösende Erreger isolieren und identifizieren können [Heim et al., 2020].
Hafnia alvei
Dieses gramnegative, fakultativ anaerobe Stäbchenbakterium gilt als weithin harmloser Darmbewohner. Der Keim wird selten als Erreger für Infektionen verantwortlich gemacht. In der Literatur wird in einzelnen Kasuistiken von Harnwegsinfektionen, Pneumonien, Katheterinfektionen und nosokomial erworbenen Infektionsgeschehen berichtet [Günthard und Pennekamp, 1996].
Das Bakterium aus der Ordnung der Enterobacterales isolierten wir aus einem perimandibulären Abszess eines gesunden 53-jährigen Patienten, der in Intubationsnarkose operiert und insgesamt vier Tage unter stationären Bedingungen behandelt wurde. Hafnia alvei zeigte in diesem Fall Antibiotikaresistenzen gegen Ampicillin, Ampicillin/Sulbactam (Unacid = das von uns verwendete empirische Breitspektrumantibiotikum) und Piperacillin/Tazobactam. Nach unserer Recherche ist dieser der bisher erste beschriebene Fall, der als Auslöser eines odontogenen Abszesses beschrieben wurde.
Nocardia asiatica
Dieser gramnegative, stäbchenförmige und säurefeste bakterielle Erreger kommt ubiquitär im Boden und in feuchten Biotopen vor. Es ist eine ganze Reihe von Erregern aus der Familie der Nocardien bekannt, die meist im Sinne einer „Nocardiose“, immunsupprimierte Patienten befallen.
Bekannt ist beispielsweise die Infektion durch in Blumenerde – besonders tropischer Pflanzen – vorkommenden Nocardien, die in die Lunge gelangen und von hier aus Infektionen auslösen können. Die Literatur weist hier vor allem auf eine Reihe von schwer verlaufenden Befällen des zentralen Nervensystems, Enzephalitiden und fulminante Hirnabszesse hin [Uneda et al., 2016]. Als Auslöser eines odontogenen Abszesses ist Nocardia asiatica bisher noch nicht Erscheinung getreten.
In unserem Fall wurde eine weitestgehend gesunde 81-jährige Frau mit einem perimandibulären Abszess operiert und vier Tage stationär behandelt. Die Arbeitsdiagnose legte nahe, dass die Bakterien wahrscheinlich pulmonal in den Wirt eintraten und sich hämatogen ausbreiteten. Es zeigten sich allerdings keine Antibiotikaresistenzen.
Cladophialophora bantiana
Hierbei handelt es sich um einen Pilzerreger, der sich von organischem Material ernährt (Saprophyt) und als Auslöser einer sogenannten Phäohyphomykose (chronische Haut- und Unterhautinfektion durch pigmentierte Pilze) verantwortlich sein kann. Der Erreger kann ubiquitär im Boden gefunden werden.
In der Literatur sind über chronische Hautinfektionen hinaus etwa 130 Fälle von häufig fatal verlaufenden Gehirnabszessen bekannt [Suri et al., 2014]. In den meisten Fällen scheint der Mykoseerreger über die Atemluft aufgenommen zu werden und kann sich über die Nebenhöhlen auf einem direkten Infektionsweg im Hirn ansiedeln und dort verbreiten. Neben immunsupprimierten Patienten ist die Infektion und Ausbreitung intrazerebral von immunkompetenten Menschen beschrieben.
Im vorliegenden Fall wurde der Erreger aus einem submandibulären Abszess eines 43-jährigen Mannes mit ausgeprägter Adipositas und einer floriden Psoriasis vulgaris isoliert. Er musste sechs Tage lang stationär behandelt werden, erhielt allerdings keine Antimykotika.
Die oben erwähnten Erreger sind nur ein kleiner Auszug aus einer breiten Palette möglicher Mikroorganismen, die in odontogenen Abszessgeschehen identifiziert werden können. Es darf allerdings nicht in Vergessenheit geraten, dass die Identifizierung dieser Keime mittels Abstrich geschieht. Nach Abstrichnahme bedarf es dann der Anzüchtung des jeweiligen Erregers, was mitunter nicht unkompliziert ist (Abbildungen 1 und 6). Bei stets polymikrobiellen Abszessinhalten ist daher die Aussage bezüglich eines bestimmten einzelnen auslösenden Erregers nur selten möglich. Eben dies gilt natürlich auch für die oben genannten Pathogene.
Patientenfall
Eine 21-jährige, gesunde Patientin stellte sich mit einer ausgeprägten Schwellung der Wange in der Klinik für Mund-, Kiefer- und Plastische Gesichtschirurgie des Uniklinikums Bonn vor. Einige Tage zuvor waren alio loco alle Weisheitszähne entfernt worden. Der Wangenabszess wurde umgehend eröffnet, gespült und drainiert. Zusätzlich wurde die Patientin mit Unacid intravenös behandelt. Intraoperativ wurde ein Abstrich gewonnen.
Die klinische Situation schien sich in den darauffolgenden Tagen zu verbessern, verschlechterte sich dann aber wieder zunehmend. Im Verlauf konnte in der Mikrobiologie der Erreger „klebsiella pneumoniae“ nachgewiesen werden, der gegen Ampicillin eine Resistenz aufwies. Am sechsten postoperativen Tag stellten wir die Antibiose dann auf Metronidazol und Ciprofloxacin um. Erst diese Umstellung der Therapie führte zu einer langsamen Regredienz der Symptome. Die Patientin musste insgesamt 18 Tage lang unter stationären Bedingungen behandelt werden.
Dr. Nils Heim
Universitätsklinikum Bonn,
Klinik für Mund-, Kiefer- und Plastische Gesichtschirurgie
Venusberg – Campus 1, Haus 11, 2. OG, 53127 Bonn
Nils.heim@ukbonn.de
Prof. Dr. Dr. Franz-Josef Kramer
Universitätsklinikum Bonn,
Klinik für Mund-, Kiefer- und Plastische Gesichtschirurgie
Venusberg – Campus 1, Haus 11, 2. OG, 53127 Bonn
Fazit für die Praxis
Der Ausheilung eines Abszessgeschehens liegt stets die suffiziente Eröffnung und Drainage der Abszesshöhle zugrunde.
Odontogene Abszesse sind in aller Regel ein polymikrobielles Geschehen. Bei Faktoren, die eine stationäre Behandlung bedingen (Zeichen einer systemischen Infektionsausbreitung oder immunsupprimierende Zustände), sollte eine additive antibiotische Therapie mit kalkulierter Antibiose eingeleitet werden.
Ein Abstrich aus der Abszesshöhle sollte durchgeführt werden, um bei Therapieversagern unter kalkulierter Antibiotikatherapie einen Präparatwechsel nach Antibiogrammergebnis durchführen zu können.
Literaturliste
1. Heim N, Jürgensen B, Kramer FJ, Wiedemeyer V. Mapping the microbiological diversity of odontogenic abscess: are we using the right drugs? Clin Oral Investig. 2020 May 29. doi: 10.1007/s00784-020-03350-0. Online ahead of print.
2. Heim N, Berger M, Wiedemeyer V, Reich R, Martini M. A mathematical approach improves the predictability of length of hospitalization due to acute odontogenic infection: A retrospective investigation of 303 patients. J Craniomaxillofac Surg. 2019 Feb;47(2):334-340.
3. Heim N, Faron A, Wiedemeyer V, Reich R, Martini M. Microbiology and antibiotic sensitivity of head and neck space infections of odontogenic origin. Differences in inpatient and outpatient management. J Craniomaxillofac Surg. 2017 Oct;45(10):1731-1735.
4. Günthard H, Pennekamp A. Clinical significance of extraintestinal Hafnia alvei isolates from 61 patients and review oft he literature. Clinical infectious Diseases. 1996 22:1040-1045.
5. Uneda A, Suzuki K, Okubo S, Hirashita K, Yunoki M, Yoshino K. Brain abscess caused by Nocardia asiatica. Surg Neurol Int. 2016 7:74.
6. Suri P, Chhina DK, Kaushal V, Kaushal RK, Singh J. Cerebral phaeohyphomycosis due to Cladophyalophora bantiana – A case report and review of literature from India. J Clin Diagn Res. 2014;8:DD1-DD05.